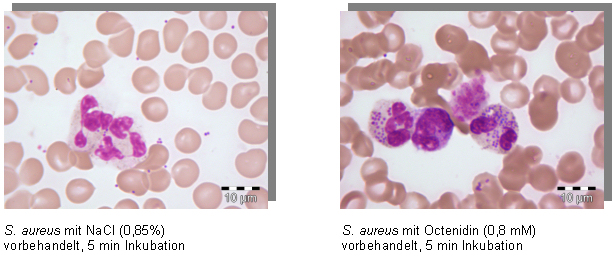

Einfluss von Octenidin auf die Phagocytose von "Stapylococcus aureus" durch neutrophile Granulocyten
Katrin Steinhauer 1Peter Goroncy-Bermes 1
1 Schülke & Mayr GmbH, Research and Development, Norderstedt, Deutschland
Zusammenfassung
Bei Gram-positiven Bakterien stellt die Veresterung der Teichonsäuren mit D-Alanin und die daraus resultierende Änderung der negativen Nettoladung der Zellwand einen Schutzmechanismus vor dem Angriff kationischer Wirkmoleküle dar.
Unsere Untersuchungen zeigen, dass auch für den kationischen Wirkstoff Octenidindihydrochlorid eine Assoziation mit der bakteriellen Zellwand in Abhängigkeit von der negativen Nettoladung angenommen werden kann. Untersuchungen der Vitalität der Bakterien nach Inkubation mit dem Wirkstoff Octenidindihydrochlorid zeigen aber, dass dieser Mechanismus keinesfalls die Penetration des kationischen Wirkstoffs durch den Mureinsacculus verhindern kann, sondern die Penetration des Wirkstoffs durch die Peptidoglycanschichten zu einer letalen Schädigung der Bakterienzellen führt.
Weiterhin konnte gezeigt werden, dass die Interaktion von Octenidindihydrochlorid mit der bakteriellen Zellwand zu einer verbesserten Phagocytose von Staphylococcus aureus durch humane neutrophile Granulocyten führt.
Schlüsselwörter
Octenidindihydrochlorid, pH-Abhängigkeit, Wirkmechanismus, Phagocytose
Einleitung
Die Zellwand stellt für die bakterielle Zelle einen wichtigen Schutz vor äußeren Einflüssen dar. Neben dem Peptidoglycan (Murein) bilden die polyanionischen Teichonsäuren einen wichtigen Bestandteil der Zellwand Gram-positiver Bakterien. Dabei kann unterschieden werden zwischen den Teichonsäuren, die kovalent mit dem Peptidoglycan assoziiert vorliegen („wall teichoic acid“, WTA) und den Lipoteichonsäuren („lipoteichoic acid“, LTA), die als Macroamphiphile mittels eines Glycolipidankers in der Cytoplasmamembran verankert vorliegen [1].
Die negative Nettoladung der Zellwand Gram-positiver Bakterien wird durch die Veresterung der anionischen Teichonsäuren mit kationischen D-Alanylresten in einer pH-abhängigen Reaktion gesteuert [2]. Dabei resultiert die bei niedrigem pH (<7) erfolgende Veresterung der Teichonsäuren mit D-Alanin in einer niedrigen negativen Nettoladung der bakteriellen Zellwand, wogegen bei höherem pH (>7) keine Veresterung erfolgt. Weiterhin wird durch die Instabilität der Esterbindung bei alkalischem pH die Erhöhung der negativen Nettoladung der bakteriellen Zellwand begünstigt (t1/2 bei pH 8 und 37°C für D-Alanyl-LTA von L. rhamnosus ist 3,9 h) [3]. Folglich wird auf diese Weise die Assoziation kationischer Substanzen wie antimikrobieller Peptide oder kationischer Wirkstoffe an die bakterielle Zellwand beeinflusst. So wiesen Peschel et al. [4] nach, dass in Mutanten von Staphylococcus aureus mit erhöhter Empfindlichkeit gegenüber kationischen antimikrobiellen Peptiden die kationischen D-Alaninester an den Teichonsäuren fehlen.
Unsere Daten zeigen, dass auch die Empfindlichkeit von S. aureus gegenüber dem kationischen Wirkstoff Octenidindihydrochlorid dieser pH-Abhängigkeit unterliegt, wobei Experimente zur Vitalität von S. aureus eindeutig zeigen, dass auch bei niedriger negativer Nettoladung der Zellwand der Wirkstoff Octenidindihydrochlorid voll wirksam ist. Des Weiteren wurde die Fragestellung untersucht, ob die Bindung von Octenidindihydrochlorid an die Zellwand von S. aureus deren Phagocytose durch neutrophile Granulozyten beeinflusst.
Material und Methoden
Für die Untersuchungen wurden Staphylococcus aureus ATCC 6538 sowie die Δdlt-Mutante S. aureus AG 1, die in der Veresterung der Teichonsäuren defizient ist, und ein isogener Wildtyp S. aureus Sa 133 verwendet [4].
Alle Stämme wurden in gepufferter Trypton-Soja-Flüssigkultur (TSB) angezüchtet, deren pH entweder auf pH 5 oder pH 8 eingestellt war. Kulturbedingungen waren 18 h bei 36±1°C. S. aureus AG 1 wurde in Gegenwart von 100 µg/ml Spectinomycin kultiviert.
Die quantitativen Suspensionsversuche wurden gemäß DGHM-Standardmethoden durchgeführt [5].
Die LIVE/DEAD Experimente erfolgten mit dem BacLightTM Bacterial Viability Kit (Molecular Probes, Eugene, OR, USA) gemäß Herstellerangaben.
Für die Phagocytose-Experimente wurden je 50 µl mit 0,8 mM Octenidindihydrochlorid- oder mit 0,85% NaCl-Lösung vorbehandelte Bakterienzellen von S. aureus ATCC 6538 mit 450 µl frischem heparinisierten humanen Vollblut bei 37°C inkubiert. Nach der angegebenen Inkubationszeit wurde von den Proben ein Blutausstrich angelegt. Nach der Trocknung wurden die Blutausstriche nach Pappenheim gefärbt und mikroskopisch ausgewertet.
Ergebnisse
Die Anzucht Gram-positiver Bakterien führt bei pH >7 bei niedrigen Konzentrationen von Octenidindihydrochlorid (0,16 mM) zu einer größeren Empfindlichkeit gegenüber diesem kationischen Agenz (Abbildung 1 [Abb. 1]). Die Experimente mit der D-Alanyl-Ester defizienten Mutante AG1 von S. aureus zeigen weiterhin, dass der Anteil der D-Alanin-Veresterung der Teichonsäuren offensichtlich die Empfindlichkeit Gram-positiver Bakterien gegenüber diesem kationischen Wirkstoff beeinflusst (Abbildung 2 [Abb. 2]).
Abbildung 1: Wirksamkeit von Octenidin (0.16 mM (0.01%) gegen
S. aureus
ATCC 6538, Flüssigkultur

Abbildung 2: Wirksamkeit von Octenidin (0.16 mM (0.01%)) gegen
S. aureus
AG1, Flüssigkultur pH 5

Die Untersuchung der Vitalität der bakteriellen Zellen nach Einwirkung verschiedener Konzentrationen von Octenidindihydrochlorid (0,001%-0,1%) zeigen dagegen, dass trotz niedriger negativer Nettoladung (wt Sa 113) innerhalb einer kurzen Einwirkzeit von 5 min die Vitalität der Bakterienzellen erheblich beeinträchtigt wird (deutliche Zunahme der toten, rot gefärbten Zellen) (Abbildung 3 [Abb. 3]).
Abbildung 3: Vitalität von
S. aureus
Sa 113 nach Inkubation mit Octenidin (0,001%-0,1%, 5 min.), LIVE/DEAD-Färbung

Abbildung 4 [Abb. 4] zeigt, dass S. aureus-Zellen, die mit Octenidindihydrochlorid (0,8 mM) vorbehandelt wurden, im Gegensatz zu mit NaCl (0,85%) vorbehandelten Bakterienzellen bereits nach 5-minütiger Inkubation mit humanem Vollblut von den neutrophilen Granulozyten signifikant besser phagocytiert werden.
Abbildung 4: Phagocytose von
S. aureus
durch neutrophile Granulocyten in humanem Vollblut
Diskussion
Die Ergebnisse zeigen, dass der bereits für andere kationische Wirkstoffe (antimikrobielle Peptide, Vancomycin, Glycopeptide) gezeigte Wirkmechanismus der Assoziation mit der Zellwand Gram-positiver Bakterien auch für Octenidindihydrochlorid postuliert werden kann (4,6). Dabei spielt die negative Nettoladung der bakteriellen Zellwand infolge der D-Alanyl-Veresterung der Teichonsäuren eine entscheidende Rolle. In unseren Experimenten war der wt Sa 113 nach Anzucht bei pH 5 weniger empfindlich gegenüber Octenidindihydrochlorid als die D-Alanyl-Ester defiziente Mutante AG1. Damit kann die Zellwand und ihre von der Veresterung mit D-Alanin abhängige Nettoladung als erster Angriffspunkt des kationischen Wirkstoffs Octenidindihydrochlorid postuliert werden. Die Modifikation der Zellwand durch Änderung der Nettoladung (z. B. in Abhängigkeit vom pH-wert des Mediums) stellt damit eine bis zu einem gewissen Grad effiziente Verteidigungsstrategie Gram-positiver Bakterien dar (1). Allerdings zeigen die Untersuchungen der Vitalität der bakteriellen Zellen nach Einwirkung verschiedener Konzentrationen von Octenidindihydrochlorid, dass dieser Mechanismus keinesfalls die Penetration des kationischen Wirkstoffs durch den Mureinsacculus verhindern kann. So zeigt die Rotfärbung der Zellen nach Inkubation mit 0,1% Octenidindihydrochlorid eindeutig die Zerstörung der Cytoplasmamembran infolge der Octenidinpenetration durch die Peptidoglycanschichten.
Diese Schädigung der bakteriellen Zellen führt des Weiteren ganz offensichtlich zu einer erhöhten Phagocytose von S. aureus durch neutrophile Granulyocten, wie die Experimente mit humanem Vollblut eindrucksvoll zeigen.
Die Schädigung der Bakterienzelle durch den kationischen Wirkstoff Octenidindihydrochlorid resultiert damit in einer Verbesserung der Phagocytose von S. aureus durch humane neutrophile Granulocyten und kann somit den Wundheilungsprozeß bei Infektionen positiv unterstützen.
Danksagung
Die Autoren danken Andreas Peschel für die freundliche Überlassung der Stämme S. aureus AG 1 und Sa 113.
Nadine Harbs, Stina Degenhardt, Daniel Zahn und Thorsten Freytag wird für die exzellente technische Unterstützung gedankt.
Literatur
[1] Neuhaus FC, Baddiley J. A continuum of anionic charge: Structures and functions of D-Alanyl-Teichoic acids in Gram-positive bacteria. Microbiol Mol Biol Rev. 2003;67:686-723.[2] Ellwood DC, Tempest DW. Influence of culture pH on the content and composition of teichoic acids in the walls of Bacillus subtilis. J Gen Micriobiol. 1972;73:395-402.
[3] Childs WC, Neuhaus FC. Biosynthesis of D-alanyl-lipoteichoic acid: characterization of ester-linked D-alanine in the in vitro-sythesized product. J Bacteriol. 1980;43:293-301.
[4] Peschel A, Otto M, Jack RW, Kalbacher H, Jung G, Götz F. Inactivation of the dlt operon in staphylococcus aureus confers sensitivity to defensins, protegrins, and other antimicrobial peptides. J Biol Chem. 1999;274:8405-10.
[5] Gebel J, Werner H-P, Kirsch-Altena A, Bansemir K. Standardmethoden der DGHM zur Prüfung chemischer Desinfektionsverfahren. Wiesbaden: mhp; 2001.
[6] Peschel A. How do bacteria resist human antimicrobial peptides? Trends in Microbiology. 2002;10:179-86.



